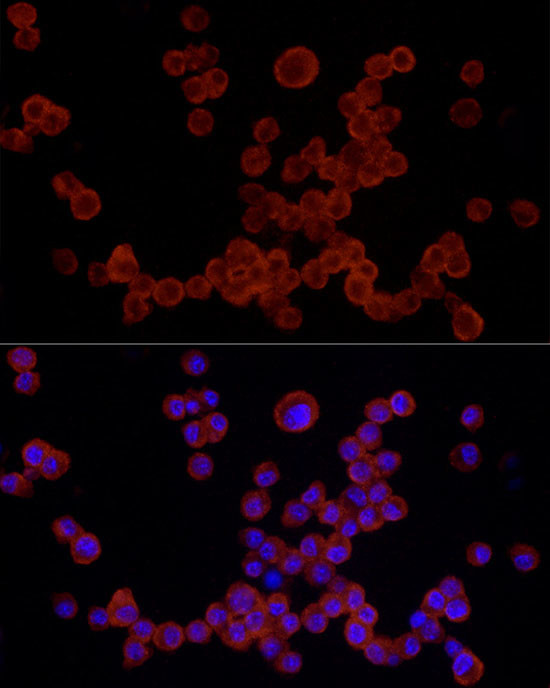
NLRP3 Antibody in Immunocytochemistry (ICC/IF)

Search
Invitrogen
NLRP3 Polyclonal Antibody
{{$productOrderCtrl.translations['antibody.pdp.commerceCard.promotion.promotions']}}
{{$productOrderCtrl.translations['antibody.pdp.commerceCard.promotion.viewpromo']}}
{{$productOrderCtrl.translations['antibody.pdp.commerceCard.promotion.promocode']}}: {{promo.promoCode}} {{promo.promoTitle}} {{promo.promoDescription}}. {{$productOrderCtrl.translations['antibody.pdp.commerceCard.promotion.learnmore']}}

Please note: We are reviewing Western blot images included in the antibody testing data in our catalog, including those provided by third parties. Unless expressly labeled or annotated as “raw-unedited”, Western blot images included in the antibody testing data in our catalog may have been edited, optimized or otherwise adjusted for presentation.
产品信息
PA5-88709
种属反应
已发表种属
宿主/亚型
分类
类型
抗原
偶联物
形式
浓度
规格
纯化类型
保存液
内含物
保存条件
运输条件
RRID
产品详细信息
Positive Samples: U-937; Cellular Location: Cytoplasm, Endoplasmic reticulum, Inflammasome, Nucleus, cytosol
Immunogen sequence: MKMASTRCKL ARYLEDLEDV DLKKFKMHLE DYPPQKGCIP LPRGQTEKAD HVDLATLMID FNGEEKAWAM AVWIFAAINR RDLYEKAKRD EPKWGSDNAR VSNPTVICQE DSIEEEWMGL LEYLSRISIC KMKKDYRKKY RKYVRSRFQC IEDRNARLGE SVSLNKRYTR LRLIKEHRSQ QEREQELLAI GKTKTCESPV SPIKMELLFD PDDEHSEPVH
靶标信息
This gene encodes a pyrin-like protein containing a pyrin domain, a nucleotide-binding site domain, and a leucine-rich repeat motif. This protein interacts with the apoptosis-associated speck-like protein PYCARD/ASC, which contains a caspase recruitment domain, and is a member of the NALP3 inflammasome complex. This complex functions as an upstream activator of NF-kappaB signaling, and it plays a role in the regulation of inflammation, the immune response, and apoptosis. Mutations in this gene are associated with familial cold autoinflammatory syndrome, and neonatal-onset multisystem inflammatory disease. Multiple alternatively spliced transcript variants encoding distinct isoforms have been identified for this gene. Alternative 5' UTR structures are suggested by available data; however, insufficient evidence is available to determine if all of the represented 5' UTR splice patterns are biologically valid.
仅用于科研。不用于诊断过程。未经明确授权不得转售。
生物信息学
蛋白别名: cold autoinflammatory syndrome 1 homolog; Cold autoinflammatory syndrome 1 protein homolog; Cryopyrin; FLJ95925; mast cell maturation inducible protein 1; Mast cell maturation-associated-inducible protein 1; NACHT, LRR and PYD domains-containing protein 3; NACHT/LRR/pyrin domain-containing protein 3; PYRIN-containing APAF1-like protein 1
基因别名: AGTAVPRL; AII/AVP; Cias1; FCAS; FCU; Mmig1; MWS; NALP3; Nlrp3; Pypaf1
UniProt ID: (Rat) D4A523, (Mouse) Q8R4B8
Entrez Gene ID: (Rat) 287362, (Mouse) 216799